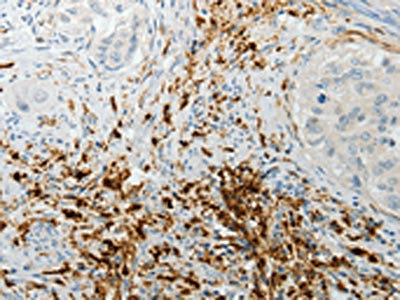

F13A1 Antibody
-
中文名稱:F13A1兔多克隆抗體
-
貨號:CSB-PA285910
-
規(guī)格:¥1100
-
圖片:
-
The image on the left is immunohistochemistry of paraffin-embedded Human cervical cancer tissue using CSB-PA285910(F13A1 Antibody) at dilution 1/15, on the right is treated with fusion protein. (Original magnification: ×200)
-
The image on the left is immunohistochemistry of paraffin-embedded Human lung cancer tissue using CSB-PA285910(F13A1 Antibody) at dilution 1/15, on the right is treated with fusion protein. (Original magnification: ×200)
-
Gel: 8%SDS-PAGE, Lysate: 40 μg, Lane: Human fetal muscle tissue, Primary antibody: CSB-PA285910(F13A1 Antibody) at dilution 1/250, Secondary antibody: Goat anti rabbit IgG at 1/8000 dilution, Exposure time: 30 minutes
-
-
其他:
產(chǎn)品詳情
-
Uniprot No.:
-
基因名:
-
別名:bA525O21.1 (coagulation factor XIII; A1 polypeptide) antibody; Coagulation factor XIII A chain antibody; Coagulation factor XIII A1 polypeptide antibody; Coagulation factor XIII A1 subunit antibody; Coagulation factor XIII; A polypeptide antibody; Coagulation factor XIIIa antibody; F13A antibody; F13A_HUMAN antibody; F13a1 antibody; Factor XIIIA antibody; Fibrin stabilizing factor; A subunit antibody; Fibrinoligase antibody; FSF; A subunit antibody; Protein glutamine gamma glutamyltransferase A chain antibody; Protein-glutamine gamma-glutamyltransferase A chain antibody; TGase antibody; Transglutaminase A chain antibody; Transglutaminase; plasma antibody; Transglutaminase. plasma antibody
-
宿主:Rabbit
-
反應(yīng)種屬:Human,Mouse
-
免疫原:Fusion protein of Human F13A1
-
免疫原種屬:Homo sapiens (Human)
-
標(biāo)記方式:Non-conjugated
-
抗體亞型:IgG
-
純化方式:Antigen affinity purification
-
濃度:It differs from different batches. Please contact us to confirm it.
-
保存緩沖液:-20°C, pH7.4 PBS, 0.05% NaN3, 40% Glycerol
-
產(chǎn)品提供形式:Liquid
-
應(yīng)用范圍:ELISA,WB,IHC
-
推薦稀釋比:
Application Recommended Dilution ELISA 1:1000-1:2000 WB 1:200-1:1000 IHC 1:15-1:50 -
Protocols:
-
儲存條件:Upon receipt, store at -20°C or -80°C. Avoid repeated freeze.
-
貨期:Basically, we can dispatch the products out in 1-3 working days after receiving your orders. Delivery time maybe differs from different purchasing way or location, please kindly consult your local distributors for specific delivery time.
-
用途:For Research Use Only. Not for use in diagnostic or therapeutic procedures.
相關(guān)產(chǎn)品
靶點詳情
-
功能:Factor XIII is activated by thrombin and calcium ion to a transglutaminase that catalyzes the formation of gamma-glutamyl-epsilon-lysine cross-links between fibrin chains, thus stabilizing the fibrin clot. Also cross-link alpha-2-plasmin inhibitor, or fibronectin, to the alpha chains of fibrin.
-
基因功能參考文獻(xiàn):
- Overall, genetically-determined FXIIIA levels have a significant long-term prognostic role, suggesting that a pharmacogenetics approach might help to select those AMI patients at risk of poor prognosis in the need of dedicated treatments. PMID: 30223472
- Inflammatory monocytes highly express Factor XIIIA, which promotes fibrin cross-linking to create a scaffold for lung squamous carcinomas cell invasion and metastases. PMID: 29777108
- Effect of factor XIII levels and polymorphisms on the risk of myocardial infarction in young patients PMID: 29484525
- Coagulation factor FXIII-A (FXIIIA) was found to express specifically in the fetal beta islets but not in the alpha/delta islets. PMID: 29424810
- Factor XIIIa (AC-1A1) is a sensitive and specific nuclear marker for sebaceous differentiation...which can be utilized to aid in the diagnosis of sebaceous neoplasms. PMID: 28873247
- Our meta-analysis supports an association between F13A1 Val34Leu and recurrent pregnancy loss. PMID: 28683377
- A brief history of some key events in the conversion of fibrinogen to fibrin has been reviewed. (Review) PMID: 27519977
- The results of this study suggest that these biomarker F13A1 can serve as a potential non-invasive early diagnosis platform reflecting PiB-PET imaging for Mild Cognitive Impairment and Alzheimer's Disease. PMID: 27392853
- F13A1 gene mutations in 73 patients treated with recombinant FXIII-A2 PMID: 28520207
- Results show that the missense mutations-causing mild FXIII de fi ciency influence different aspects of FXIII function and can be functionally categorized on the basis of their expression phenotype. PMID: 27363989
- These findings provide insight into assembly of the fibrinogen/FXIII-A2B2 complex in both physiologic and therapeutic situations. PMID: 27561317
- FXIIIa exhibits a preference for Q237 in crosslinking reactions within fibrinogen alphaC (233-425) followed by Q328 and Q366. PMID: 26951791
- factor XIII Val34Leu polymorphism is associated with coronary artery diseases risk, especially myocardial infarction. Age and sex did not affect the relationship between factor XIII Val34Leu polymorphism and diseases risk (Meta-Analysis) PMID: 27665853
- Mounting evidence now suggests that platelet FXIII-A modulates hemostasis by several different mechanisms. This condensed review discusses recent advances in the understanding of the novel intracellular and extracellular functions of platelet FXIII-A. [review] PMID: 27207415
- It is a unique case showing the combination of a highly aggressive angiosarcoma and presence of inherited FXIII deficiency. It is also a rare example demonstrating the benefit of FXIII genotyping besides the expected acquired FXIII deficiency possibly due to neoplasm induced increased consumption by elevated crosslinking of fibrin fibers. PMID: 26540128
- The Val34Leu polymorphism of FXIII was not found in Korean people, and compared with Caucasians, a noticeably low incidence of deep vein thrombosis was shown. PMID: 26802299
- Genetic basis of severe factor XIII deficiency in a large cohort of Indian patients has been uncovered. PMID: 26852661
- Our meta-analysis suggests that there is no evidence for strong association between FXIII Val34Leu polymorphisms and intracerebral hemorrhage--{review} PMID: 26121426
- Deletion of 11 or more N-terminal amino acids disrupts intersubunit interactions, which may prevent FXIII-A2 homodimer formation. AP-FXIII plays an important role in the stability of the FXIII-A2 dimer. PMID: 26083359
- Mutations in the activation peptide of full-length recombinant FXIII regulate activation rates by thrombin, and V34L influences in vivo thrombus formation by increased cross-linking of the clot. PMID: 26743168
- Different FXIII-A dynamics and levels could be utilised as early prognostic indicators during acute MI, revealing the individual potential to heal and suggesting tailored treatments to avoid heart failure or its extreme consequence. PMID: 25947356
- FXIII Val34Leu polymorphism has a protective effect against recurrent spontaneous abortion. PMID: 25862345
- Report immunochromatographic test for detection of anti-factor XIII A subunit antibodies that can diagnose 90 % of cases with autoimmune haemorrhaphilia XIII. PMID: 25740658
- These results indicate that FXIIIa activity can be modulated by fibrinolytic enzymes, and suggest that changes in fibrinolytic activity may influence cross-linking of blood proteins. PMID: 26359437
- Suggest that FXIIIa positive dermal dendrocytes may be the main antigen presenting cells in indeterminate leprosy. PMID: 25365500
- there is an evidence for association between factor XIII Val34Leu polymorphism and CSX PMID: 23677728
- These findings expose a newly recognized, essential role for fibrin crosslinking during whole blood clot formation and consolidation and establish FXIIIa activity as a key determinant of thrombus composition and size. PMID: 26324704
- Results show that FXIII-B Arg95 variant is associated with an increased risk of abdominal aortic aneurysms (AAA) suggesting a possible role for FXIII in AAA pathogenesis. PMID: 25384012
- The results demonstrate that FXIII-A Val34Leu polymorphism does not influence the occurrence of atherothrombotic ischemic stroke, but has an effect on the severity of its outcome. PMID: 24686102
- His343Gln was a novel missense mutation occurring in the core domain of the FXIII A subunit. This is the first report of genetically confirmed FXIII deficiency in Korea, with novel and recurrent F13A1 mutations. PMID: 25004025
- study suggested that FXIIIA Val34Leu polymorphism was a protective factor for myocardial infarction in caucasians PMID: 24042156
- Genotype 163TT of FXIII-A gene as a new independent risk factor for the development of Venous Thromboembolism in young women living in the North-West region of Russia. PMID: 26035561
- This study presents the covalent structure of single-stranded fibrin oligomers cross-linked by FXIIIa. PMID: 25896761
- a cohort of 27 individuals was analysed and four novel mutations leading to congenital FXIII deficiency were reported PMID: 24329762
- FXIII-A has a functional role through exposure on the activated platelet membrane where it exerts antifibrinolytic function by cross-linking alpha2AP to fibrin PMID: 25331118
- 8 new heterozygous missense mutations (Pro166Leu, Arg171Gln, His342Tyr, Gln415Arg, Leu529Pro, Gln601Lys, Arg703Gln and Arg715Gly) may affect catalysis, barrel domain integrity or activation peptide cleavage, depending on domain. PMID: 24889649
- results demonstrate the utility of eQTL mapping in the identification of novel asthma genes and provide evidence for the importance of FADS2, NAGA, and F13A1 in the pathogenesis of asthma. PMID: 24934276
- FXIII Val34Leu and PAI-1 4G/5G polymorphisms are prevalent in Egyptian women, with unexplained primary first trimester Recurrent miscarriage and combined polymorphisms statistically increasing the risk. PMID: 24702949
- FXIII-A serves as a preadipocyte-bound proliferation/differentiation switch that mediates effects of hepatocyte-produced circulating pFN. PMID: 24934257
- plasma FN assembly into bone matrix in vitro requires FXIIIA transglutaminase activity making pFN assembly an active, osteoblast-mediated process. PMID: 24246248
- this study presents for the first time an in depth and time-resolved analysis of the FXIIIa substrate proteome in plasma. PMID: 24443567
- Patients with advanced-stage NSCLC exhibited higher coagulation FXIII activity than healthy controls and early-stage NSCLC patients. PMID: 24142643
- These data suggest that plasma transglutaminase factor XIII may play a key role in fetal development of vertebrates via cross-link of Fas antigen. PMID: 24216108
- Data suggest that Factor XIII (composed of subunits F13A and F13B) increases rigidity/strength of fibrin clot, protects fibrin clot against shear stress in circulation, and protects fibrin from prompt elimination by fibrinolytic system. [REVIEW] PMID: 24476525
- Studies indicate that mutations in the factor XIII-A (FXIII-A) gene causing congenital factor XIII deficiency. PMID: 23929307
- Overproduction of FXIII-A by M2 macrophages might contribute to the excessive fibrin deposition in the submucosa of nasal polyps (NP), which might contribute to the tissue remodeling and pathogenesis of chronic rhinosinusitis with NP. PMID: 23541322
- The Fctor XIIIa R260C mutant has significantly altered conformations, resulting in the rapid degradation by the proteasome inside the synthesizing cells PMID: 23279035
- No association has been found between FXIII-A Val34Leu genotype and the risk for peripheral arterial disease in a Hungarian cohort of patients. PMID: 23518792
- The prevalence of a F13A1 gene intron 1 variant (IVS1+12C>A) was found with greater frequency in patients with a mild FXIII deficiency with no detectable F13A1 or F13 B mutations than in those with heterozygous F13A1 mutations or in normal controls. PMID: 23508224
- The results suggest an increase in FXIII activity as the number of repetitions of the short tandem repeat polymorphism in the F13A01 gene increased up to allele 5. PMID: 22909824
顯示更多
收起更多
-
相關(guān)疾病:Factor XIII subunit A deficiency (FA13AD)
-
亞細(xì)胞定位:Cytoplasm. Secreted. Note=Secreted into the blood plasma. Cytoplasmic in most tissues, but also secreted in the blood plasma.
-
蛋白家族:Transglutaminase superfamily, Transglutaminase family
-
數(shù)據(jù)庫鏈接:
Most popular with customers
-
-
YWHAB Recombinant Monoclonal Antibody
Applications: ELISA, WB, IHC, IF, FC
Species Reactivity: Human, Mouse, Rat
-
Phospho-YAP1 (S127) Recombinant Monoclonal Antibody
Applications: ELISA, WB, IHC
Species Reactivity: Human
-
-
-
-
-